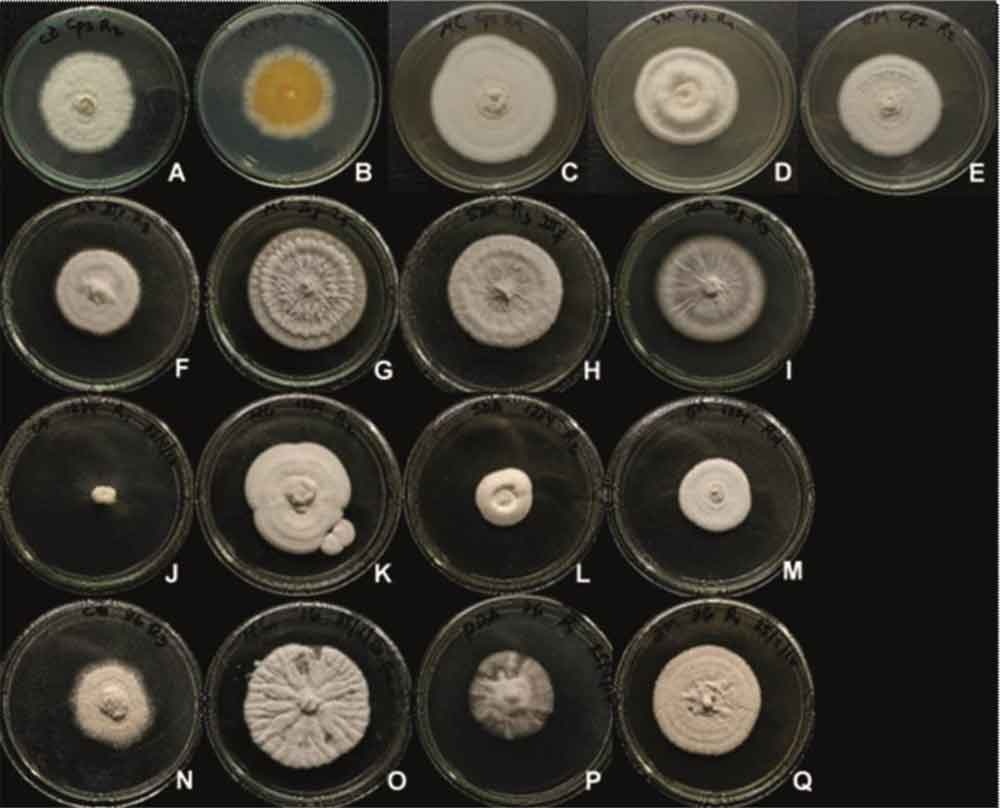
Morfología de las colonias de los aislados de Beauveria en diferentes medios de cultivo a los 10 días de crecimiento. LBb-Cp2: A-CDA, B-CDA reverso, C-MC, D-SDA, E-MEA; LBb-IIIf: F-CDA, G-MC, H-SDA, I-MEA; LBb-1234: J-CDA, K-MC, L-SDA, M-MEA; LBb-76: N-CDA, O-MC, P-SDA, Q-MEA.

Publicado: 2024-01-01
Artículos Originales
Determinación del efecto rodenticida de Lantana aculeata var parviflora sobre ratones de la especie Mus musculus L.
https://cu-id.com/2109/v27e02
Efectividad del cebo rodenticida de hojas de Lantana camara L var camara f portorrisencis
https://cu-id.com/2109/v27e03
Preferencia de hospedante de Raoiella indica (Acari:Tenuipalpidae) en condiciones de laboratorio
https://cu-id.com/2109/v27e04
Ácaros asociados a los productos almacenados de la industria molinera del municipio Regla
https://cu-id.com/2109/v27e05
Respuesta de cultivares de caña de azúcar a Puccinia kuehnii (KRÜGER) en Mayabeque
https://cu-id.com/2109/v27e06
Caracterización de cuatro aislados cubanos de Beauveria spp. con perspectivas para el control de plagas agrícolas
https://cu-id.com/2109/v27e08
Evolución y situación actual de las enfermedades virales en el cultivo del tomate (Solanum lycopersicum, L.) en Cuba
https://cu-id.com/2109/v27e09
Caracterización del diseño y manejo de la biodiversidad auxiliar en fincas suburbanas
https://cu-id.com/2109/v27e10
Nemátodos entomopatógenos en el manejo de Plutella xylostella L. (palomilla del dorso dorado)
https://cu-id.com/0378/v27e13
Moluscos asociados a sistemas de hortalizas semiprotegidas del municipio de Morón, Ciego de Ávila
https://cu-id.com/2109/v27e16
Comunicaciones Cortas
La cabeza loca del maíz causada por Sclerophthora macrospora en Cuba
https://cu-id.com/2109/v27e11